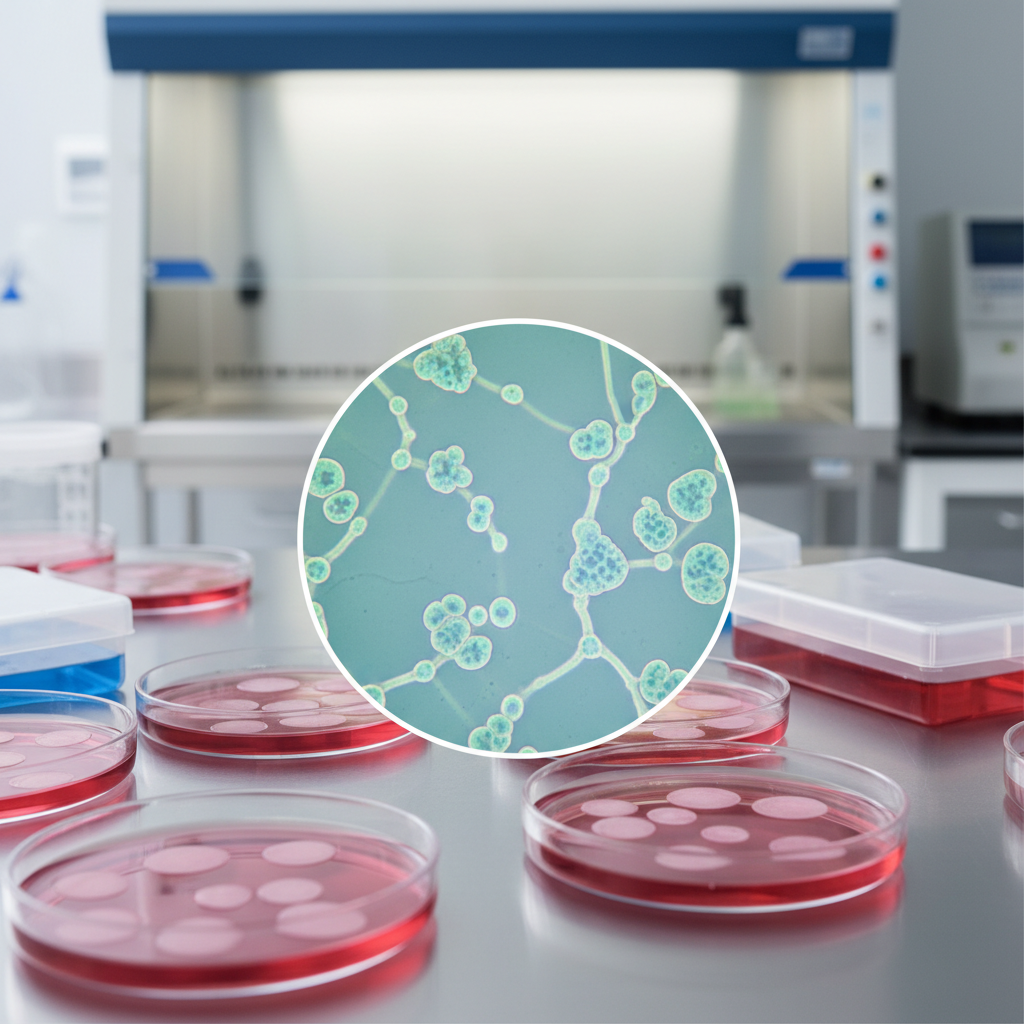

Stem Cell Therapy for Ischemic Heart Disease | 2026 Research
Explore stem cell applications in cardiovascular disease. Learn about isolation protocols, clinical efficacy, LVEF improvement, and heart tissue regeneration.
Stem Cell Applications in Cardiovascular Disease
Protocols, Isolation, and Efficacy in Ischemic Heart Disease (IHD)
Medical Research Overview | 2026
What Are Stem Cells?
Stem cells are undifferentiated biological cells defined by three key properties: self-renewal (dividing to make identical copies), clonogenicity (ability to form clones), and multipotentiality (capability to differentiate into specialized cell types). In the context of the heart, they can transform into cardiomyocytes, endothelial cells, smooth muscle cells, and fibroblasts.
Types of Stem Cells for Heart Repair
Cardiac Stem Cells (CSCs): Tissue-specific residents, often identified as c-kit positive cells.
Bone Marrow-Derived Cells (BMCs): Includes CD34+ hematopoietic stem cells mobilized for repair.
Induced Pluripotent Stem Cells (iPSCs): Reprogrammed adult cells capable of differentiating into cardiac lineages.
Mesenchymal Stem Cells (MSCs): Sourced from marrow or adipose tissue, known for immunomodulation.
The Cardiac Niche
Stem cells reside in specific microenvironments known as 'niches'. Within the heart, these niches regulate the turnover of cardiomyocytes. The cells are structurally connected via gap and adherens junctions, allowing for electrical and mechanical integration essential for synchronized heart function.
Mechanisms of Action
Stem cells operate via hierarchical regeneration: progressing from stem cells to progenitor cells, then amplifying cells, and finally terminally differentiated myocytes. Key mechanisms include direct differentiation into heart muscle and vessels, improvement of mechanical/electrical properties, and paracrine signaling to reduce stress.
Focus Disease: Ischemic Heart Disease (IHD)
Pathology and Regenerative Need
IHD Pathophysiology
Atherosclerosis leads to reduced coronary blood flow and oxygenation.
Prolonged ischemia causes cardiomyocyte death and ventricular dysfunction.
Conventional treatments manage symptoms but do not replace dead tissue.
Inflammation triggers the release of homing signals like SDF-1 and VEGF, attracting stem cells.
In Ischemic Heart Disease, stem cells aim to reduce infarct size and fibrosis while improving Left Ventricular Ejection Fraction (LVEF) through angiogenesis and vasculogenesis.
Therapeutic Benefits
Clinical Efficacy: LVEF Improvement
Clinical data indicates that stem cell therapy can significantly improve heart function. This chart illustrates a typical improvement in Left Ventricular Ejection Fraction (LVEF) comparing baseline measurements to 6-month post-treatment follow-ups in IHD patients.
Isolation: Cardiac Biopsy Protocol
For cardiac-derived stem cells, tissue is obtained via endomyocardial biopsy. Small samples are harvested, typically from the right ventricular septum. These samples contain resident CSCs (c-kit positive) which are then enzymatically dissociated and expanded in a laboratory setting.
Isolation: Bone Marrow Protocol (CD34+)
Less invasive than cardiac biopsy; uses apheresis to collect peripheral blood mononuclear cells.
Patients may receive G-CSF (Granulocyte-Colony Stimulating Factor) to mobilize stem cells from marrow into the bloodstream.
CD34+ cells are isolated using magnetic bead selection (MACS) or fluorescence-activated cell sorting (FACS).
These cells naturally home to sites of inflammation and ischemia.
Laboratory Expansion
Once isolated, stem cells undergo in vitro expansion. The culture environment mimics the physiological niche to maintain stemness while encouraging proliferation. This involves specialized media, hypoxia chambers, and strict quality control to ensure cells retain their regenerative potential before delivery.
Differentiation Protocols
Cells are guided to specific lineages using growth factor cocktails (e.g., VEGF, FGF).
Cardiogenic differentiation produces cells with contractile properties.
Vascular differentiation promotes formation of endothelial cells for angiogenesis.
iPSCs require careful reprogramming to avoid teratoma formation before usage.
Delivery: Intracoronary Infusion
This method involves infusing stem cells directly into the coronary artery supplying the infarcted area using an over-the-wire balloon catheter. It relies on the biological 'homing' signals (chemotaxis) released by the damaged tissue to attract the stem cells from the bloodstream into the myocardium.
Delivery: Intramyocardial Injection
Considered superior for IHD, this method utilizes an electromechanical mapping catheter to inject cells directly into the transition zone between healthy and scarred tissue (transendocardial). This ensures localized retention of cells where they are most needed, bypassing the need for homing.
Clinical Protocol Overview
Phase 1: Diagnosis and baseline imaging (MRI/Echo) to map infarct.
Phase 2: Cell Harvesting (BM or Biopsy) followed by purification/expansion.
Phase 3: Delivery via NOGA mapping (electromechanical) or catheter.
Phase 4: Follow-up monitoring for arrhythmias and functional improvement.
Reduction in Scar Tissue Mass
Beyond functional improvement, a key objective is correcting structural damage. Clinical trials observe a reduction in infarct size (scar tissue mass) in treated groups compared to controls, indicating true regeneration rather than just symptom management.
Challenges and Risks
Arrhythmogenesis: Poor electromechanical coupling between new and old cells can cause irregular heartbeats.
Cell Retention: A large percentage of injected cells may be washed away or die immediately (anoikis).
Age-Related Decline: Autologous stem cells from older patients may have reduced regenerative capacity.
Fibrosis: Breaking down established scar tissue remains biologically difficult.
Recent Advances (2026)
Recent research focuses on enhancing bone marrow cells to better reverse fibrosis and accelerate vessel formation. Additionally, iPSC-derived Cardiac Stem Cells allow for personalized therapy, reducing immune rejection risks. Combining gene editing with stem cell therapy is showing promise in preclinical models to enhance cell survival.
Future Directions in Cardiac Regeneration
Optimizing homing, cellular integration, and scaling protocols for widespread clinical application.
- stem-cell-therapy
- cardiovascular-disease
- ischemic-heart-disease
- regenerative-medicine
- medical-research
- cardiology